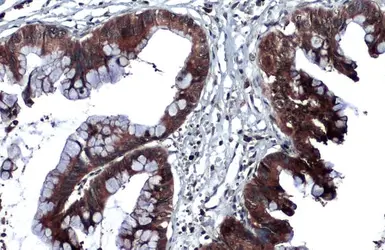
Anti-Thrombospondin 2 antibody used in IHC (Paraffin sections) (IHC-P). GTX134554

Thrombospondin 2 antibody
Cat. No. GTX134554
Cat. No. GTX134554
-
HostRabbit
-
ClonalityPolyclonal
-
IsotypeIgG
-
ApplicationsWB IHC-P
-
ReactivityHuman
Summary
Thrombospondin 2, also known as THBS2 and TSP2, is a secreted glycoprotein with a predicted molecular weight of 130 kDa. THBS2 mediates cell-to-cell and cell-to-matrix interactions, and can be expressed together with CA 19-9 in patients with early pancreatic ductal adenocarcinoma.